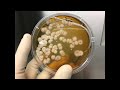

ЧТО ЕСТЬ МУЖЧИНЕ ДЛЯ ЗАЧАТИЯ РЕБЕНКА
Мужчине для зачатия ребенка играют важную роль несколько факторов:
1. Здоровье и сперматогенез: Здоровый образ жизни, умеренная физическая активность и правильное питание могут способствовать улучшению качества спермы. Важно следить за состоянием своего здоровья, чтобы иметь больше шансов на успешное зачатие ребенка.
2. Планирование беременности: Заблаговременное посещение врача, сдача необходимых анализов, исправление имеющихся проблем и лечение заболеваний могут сыграть положительную роль в процессе зачатия ребенка.
3. Сексуальная активность: Регулярные половые акты и выбор оптимального времени для зачатия, основываясь на знании о периоде овуляции, могут повысить шансы на зачатие ребенка.
4. Психологическое благополучие: Эмоциональное состояние, стресс и психоэмоциональное напряжение могут влиять на репродуктивную функцию мужчины. Поддержка партнера и забота о собственном психическом здоровье могут способствовать успешному зачатию.
В целом, мужчина играет важную роль в процессе зачатия ребенка и успешном начале семейной жизни. От здоровья до психологического благополучия, мужчина должен уделить внимание всем аспектам своей жизни, чтобы создать лучшие условия для зачатия и будущего ребенка.
Развитие плода. Беременность. Чудо зарождения жизни. Клиника Айгерим.
Зародыш человека .От зачатия до рождения. Эмбриональное развитие человека.
Витамины для мужчины перед Зачатием. Проблемы с зачатием. Врач уролог-андролог. Москва.
Стоит ли мужчине отказаться от алкоголя перед планируемым зачатием
РАК. Срочно! Невероятное Скоро Случится! тао прогноз Ноябрь 2023
Нужно ли мужчине готовиться к зачатию ребёнка?
Самая лучшая поза для зачатия ребенка